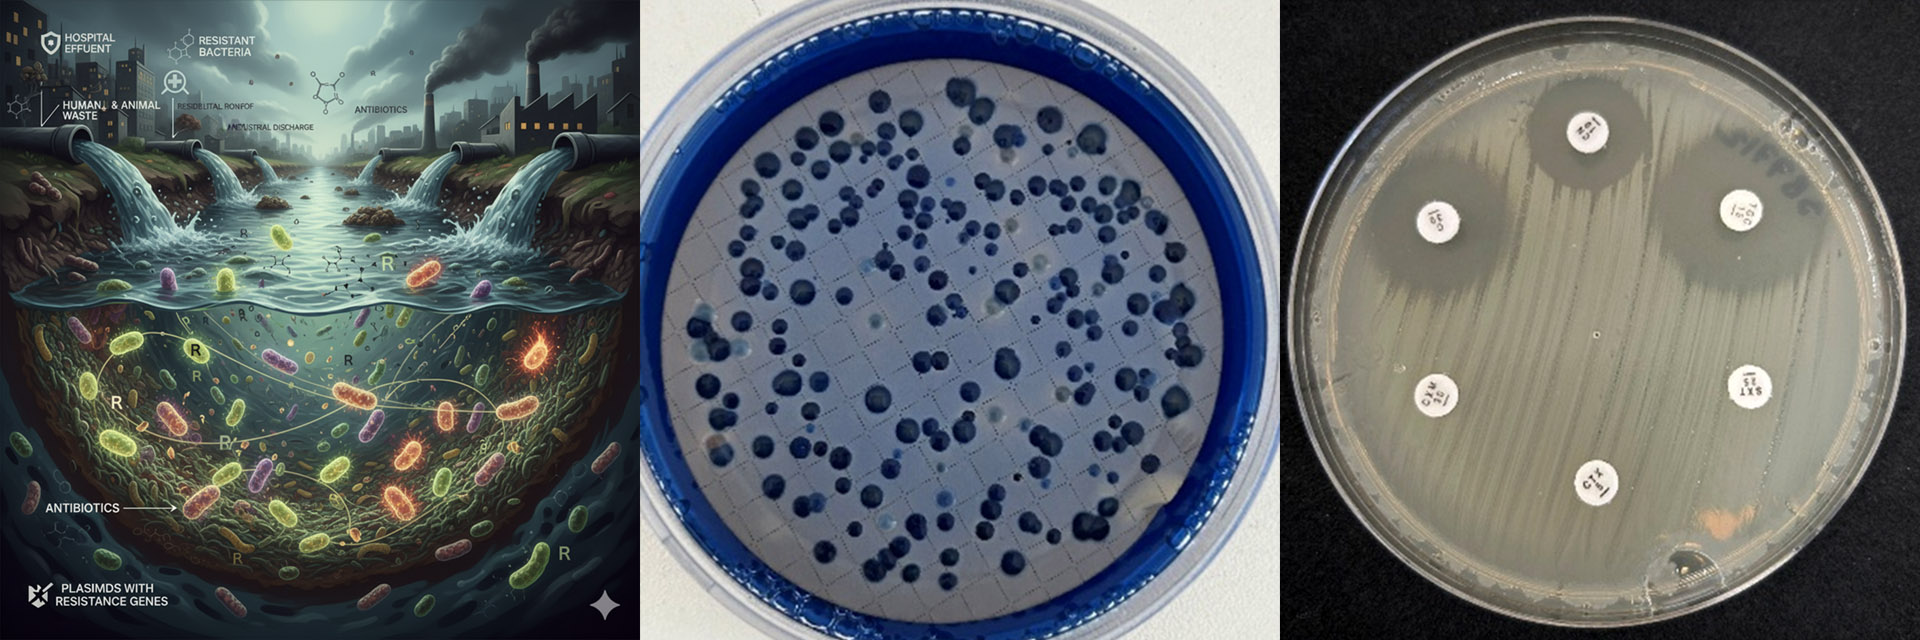

Začíná Světový týden povědomí o antimikrobiální rezistenci
Světový týden povědomí o antimikrobiální rezistenci 18.–24. 11. 2025 (World AMR Awareness Week) je kampaň WHO, zaměřená na podporu globálních opatření cílených proti vzniku a šíření patogenů rezistentních na antimikrobiální látky. Moto je v tomto roce: „Jednej teď: chraň naši přítomnost, zabezpeč naši budoucnost“ („Act Now: Protect Our Present, Secure Our Future“).
AMR je globální hrozbou, intenzívně ohrožující veřejné zdraví, která vyžaduje odvážné a jednotné kroky k jejímu snížení. Výzva naléhavě žádá všechny zúčastněné strany, včetně vlád, veřejnosti, poskytovatelů zdravotní a veterinární péče, zemědělců a orgánů v oblasti životního prostředí, aby se zodpovědně zapojily do konkrétních a účinných aktivit.
V posledních letech je nedílnou součástí boje proti AMR i životní prostředí, do něhož se rezistentní mikroorganismy dostávají, zejména odpadními vodami, a které poskytuje podmínky pro vznik nových rezistencí a jejich šíření.
Výzkumný ústav vodohospodářský, T.G. Masaryka, v.v.i. je zástupcem MŽP v aktivitách, zaměřených na sledování problematiky AMR v ČR a ve světě a od roku 2024 provádí pilotní sledování stavu ve vodním prostředí ČR.
Téma bude zařazeno na konferenci „Mikrobiologie vody a prostředí“, pořádanou VÚV a Ekomonitorem 15.–17. 4. 2026 v Malé Morávce a aktuálně na konferenci CZEPAR, konanou 19.–20. 11. 2025 v Brně.